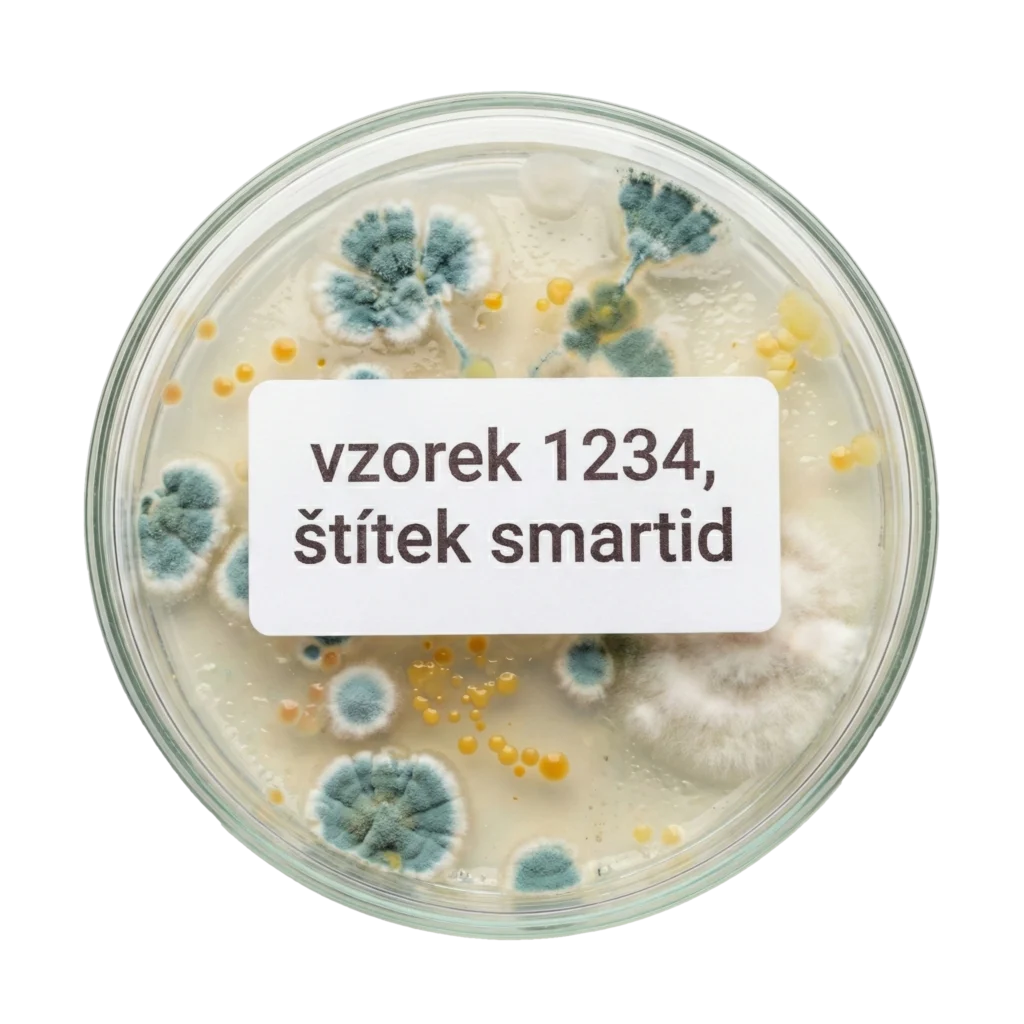

Více než nálepka
Naše řešení využívá štítky vyráběné americkou společností Brady Corporation
Ta se zaměřuje na značení do nejnáročnějších podmínek.

Tekutý dusík
Odolnost při -196°C, zachování čitelnosti a adheze i při dlouhodobém skladování v kryogenních podmínkách.

Vroucí voda
Testováno při 100°C, etikety zůstávají přilepené a čitelné i při sterilizaci.

Autokláv
Odolnost vůči tlaku a teplotám až 130 °C. Štítky zůstávají přilepené, čitelné a nedeformují se ani po opakované sterilizaci.

Chemikálie
Vysoká odolnost vůči etanolu, xylenu, izopropanolu a dalším běžným laboratorním činidlům. Text i čárové kódy zůstávají neporušené.

ZKUMAVKY

STÉBLA A TYČINKY

MIKRODESTIČKY

TKÁŇOVÉ KAZETY

LABORATORNÍ SKLO

OBECNÉ LABORATORNÍ ZNAČENÍ

PETRIHO MISKY

PODLOŽNÍ SKLÍČKA

MNOHO DALŠÍCH
Tiskárny štítků
řada M2
Perfektní volba pro laboratoře, které potřebují rychle a spolehlivě označit většinu laboratorních pomůcek. Řada M2 nabízí výběr nejdůležitějších materiálů, které s jistotou zvládnou nástrahy tekutého dusíku, mrazáků i autoklávů. Je to ideální, cenově dostupné řešení pro standardní aplikace.
- Materiály: Základní portfolio vysoce odolných štítků.
- Max. šíře tisku: 19 mm
- Varianty: M210-LAB (s klávesnicí) nebo M211 (ovládání mobilem)
řada M5
Určeno pro laboratoře, které vyžadují značení se speciálními vlastnostmi a maximální odolností. Řada M5 vám zpřístupní kompletní portfolio profesionálních materiálů Brady navržených pro specifické a extrémní situace jako jsou agresivní rozpouštědla, nebo lepení na již zmrzlé povrchy.
- Materiály: Základní i široké spektrum specialit.
- Max. šíře tisku: 38 mm
- Varianty: M510 (s klávesnicí) nebo M511 (ovládání mobilem).
Tiskárna BBP12
Když potřebujete tisknout stovky štítků najednou, přenosné tiskárny nestačí. BBP12 je kompaktní stolní tiskárna, která kombinuje ekonomický provoz s největší variabilitou materiálů.
- Materiály: Základní i široké spektrum speciálních materiálů.
- Max. šíře tisku: 110 mm
Získejte řešení na míru zdarma
Nevíte si rady s výběrem? Kontaktujte nás. Rádi s vámi probereme vaše potřeby a bezplatně pro vás navrhneme funkční systém značení přesně podle vašich požadavků.